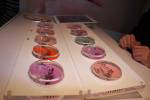

After registering as press to the Olympia Beauty Show and receiving my badge, I was delighted to finally attend the event on the 23 of September.
The exhibition is one of the “UK’s premier beauty trade events” and this year it took place at Olympia’s Grand Hall, in Kensington, London. Registration is free; but only open to therapists, salon and spa managers/owners, make up artists, hairdressers, nail technicians and beauty students.
I must mention that I was very impressed with the communications prior to the event; I received various emails with press releases, interview opportunities, and general information to enable me to make the most of my visit.
There was a media lounge and the social cloud, where attending press could talk directly to some exhibitors, swap cards, get some samples for review, as well as have a sit, have some coffee and water. There were also press releases from various companies and a few goody bags – always fun to see!
Nailed it!
This year, I have to say, it was all about nails; so many nail product stands! Gel manicures were really all the rage; lots of brands launching gel ranges, doing demos, massive queues of people wanting to have their nails done.
I am lucky to have healthy and strong natural nails, know to do my own manicures which are well finished and last in a great state for 7-10 days, so I am still a traditional nail polish gal. Plus, I get bored of the colours really easily. For all that, I haven’t bought into the shellac advantage, but I can totally see why people are going crazy for them – anything that promises busy women 14 days of nail peace is nothing short of a miracle! Even more established brands, are launching gel manicure ranges.
OPI, China Glaze, NuBAr, Minx and other big nail brands names were represented (OPI had a massive stand with own security, heaving with people!). I also met people from a cool polish brand and salon, Filthy Gorgeous, which have a line with striking colours. Their bottles come with a cute (and working!) plectrum. I was giving a lovely purple shade called Judy Baby and hope to try it soon!
Tantastic
Tan was also massive. Loads of stands offering spray tans to the exhibition attendees, in addition to selling the tools and materials of the trade. I have still to review self tanning products in the blog, so I am delighted I met Nicky from Sienna X, who offered me a sample version of a cute kit they are releasing for Christmas and also one of their gradual tans (really looking forward to trying this!), as well as a lovely bronzer I cannot wait to review, its texture is lush! They had a massive stand which was buzzing with professionals ordering for their salons – I was happy to see that, as Nicky was so lovely to me!
“The eyes have it”
Brows and lashes (fake and extensions) were well represented. Designer/stencil brow bars were everywhere, and the people responsible for the prettiest lashes ever, Paperself was also present – and doing a free application of their minis, so I left with the gorgeous Peacock (in love!). Have to say, I directed a good half a dozen people to their stand, as they asked me where my pretty lashes were from!
For the pros
Obviously, they were lots of stands with furniture e tools for salons and equipment for aesthetic face and body treatments, massages and alternative therapies.
Something I had never seen before were tanning tights. Yes, your heard it right- tanning tights. You wear them for 10 minutes, the tan transfers to your leg, afterwards, you can still wear them as normal tights!!!
Where is my make up?
The only think I missed were more make up stands. Really, I couldn’t spot many, I think I only spotted NYX and New CID! Please more make up next year!!!
The exhibition also had four live stages, with presentations on the business of beauty, creative nails, make up art and medical beauty to give professionals an all round support on their business. There were competitions – artistic make up and nails, so I spotted some wonderful designs walking around! All buzzing, very organised, a great atmosphere.
My purchases weren’t as crazy as they could have been, seriously, so much temptation!!! I bought a couple of OPI polishes, three NuBar polishes, two Minx nails foils packets, a couple pots of glitter and crunched gold and silver foils for nails of course!
Overall, I had a fantastic time and would love to go back on the second day, sadly, I work all day, but I will certainly be going back next year.
- Another overview
- Overview of the exhibition
- Full, but comfortable
- Exhibition in full swing
- Amazing and crazy nail art!
- So intricate!
- Nailympics
- Nubar… oh, the colours…
- Sienna X new products
- Minx nail wraps
- Lauren from TOWIE promoting her beauty line
- Brows!
- Lashes being applied
- The gel nail fever is contagious!
- Paperself lashes
- The prettiest lashes…
- OPI nail polishes selling like hot cakes
- A world of nail polish from China laze
- Can’t get enough of the colours!
- More Nubar polishes
- Glitter!
- All about nails…
- Make-up/beauty trolleys!
- Body spraying
- More body spraying
- Tanning tights!
- Manicure
- Massages!

Work with cats made by Ukrainian masters!!Very beautiful work!!!))
LikeLike
Its was very impressive! So detailed!! 🙂
LikeLike
Pingback: Los mejores diseños de nail art | Artistas Revelación